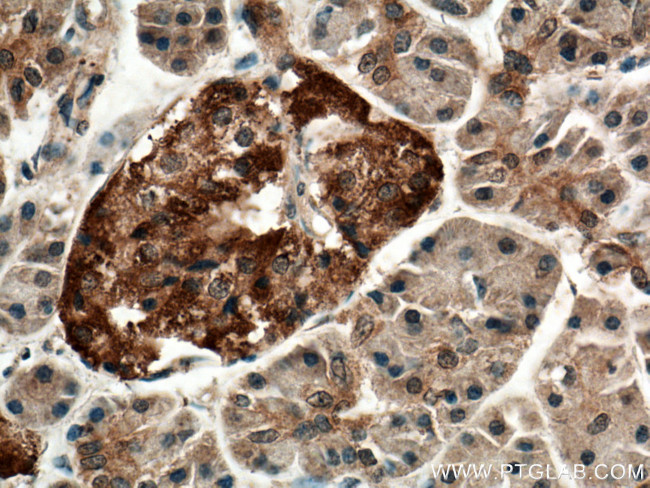
CNKSR1 Antibody in Immunohistochemistry (Paraffin) (IHC (P))

Search
Proteintech
CNKSR1 Polyclonal Antibody
{{$productOrderCtrl.translations['antibody.pdp.commerceCard.promotion.promotions']}}
{{$productOrderCtrl.translations['antibody.pdp.commerceCard.promotion.viewpromo']}}
{{$productOrderCtrl.translations['antibody.pdp.commerceCard.promotion.promocode']}}: {{promo.promoCode}} {{promo.promoTitle}} {{promo.promoDescription}}. {{$productOrderCtrl.translations['antibody.pdp.commerceCard.promotion.learnmore']}}
产品信息
10885-1-AP
种属反应
宿主/亚型
分类
类型
抗原
偶联物
形式
浓度
规格
纯化类型
保存液
内含物
保存条件
运输条件
产品详细信息
Immunogen sequence: LSLAPLSPR APSEDVFAFD LSSNPSPGPS PAWTDSASLG PEPLPIPPEP PAILPAGVAG TPGLPESPDK SPVGRKKSKG LATRLSRRRV SCRELGRPDC DGWLLLRKAP GGFMGPRWRR RWFVLKGHTL YWYRQPQDEK AEGLINVSNY SLESGHDQKK KYVFQLTHDV YKPFIFAADT LTDLSMWVRH LITCISKYQS PGRAPPPREE DCYSETEAED PDDEAGSHSA SPSPAQAGSP LHGDTSPAAT PTQRSPRTSF GSLTDSSEEA LEGMVRGLRQ GGVSLLGQPQ PLTQEQWRSS FMRRNRDPQL NERVHRVRAL QSTLKAKLQE LQVLEEVLGD PELTGEKFRQ WKEQNRELYS EGLGAWGVAQ AEGSSHILTS DSTEQSPHSL PSDPEEHSHL CPLTSESSLR PPDL (308-720 aa encoded by B C011604)
靶标信息
This gene encodes a protein containing several motifs involved in protein-protein interaction, including PDZ, PH (Pleckstrin homology), and SAM (sterile alpha motif) domains. The encoded protein acts as a scaffold component for receptor tyrosine kinase signaling and may mediate crosstalk between different signaling pathways. Alternative splicing results in multiple transcript variants.
仅用于科研。不用于诊断过程。未经明确授权不得转售。
生物信息学
蛋白别名: CNK homolog protein 1; CNK1; Connector enhancer of kinase suppressor of ras 1; Connector enhancer of KSR 1; Connector enhancer of KSR-like; unnamed protein product
基因别名: CNK; CNK1; CNKSR1
UniProt ID: (Human) Q969H4
Entrez Gene ID: (Human) 10256